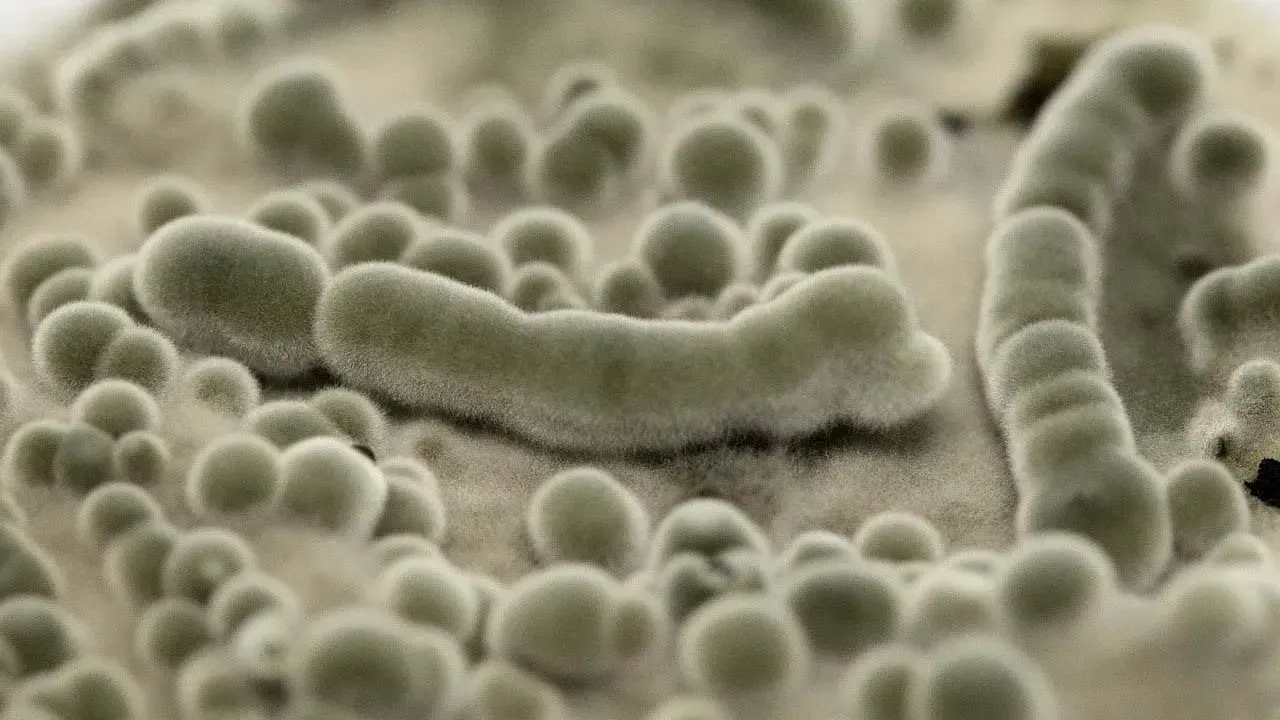

Грибок, которому не страшен Марс
Учёные давно знали, что грибки — удивительно живучие существа. Но новое исследование показало кое-что неожиданное: некоторые их виды способны пережить буквально каждый этап перелёта на Марс — и чувствовать себя там вполне сносно.
Всё началось с уборки. Перед отправкой марсохода «Персеверанс» в 2020 году специалисты NASA тщательно дезинфицировали сборочные цеха, где собирали аппарат. Несмотря на это, в помещениях обнаружили грибки — они попросту пережили обработку. Учёные решили проверить, насколько далеко заходит их выносливость.
Для эксперимента исследователи взяли споры 27 грибковых штаммов, найденных в этих цехах, и подвергли их условиям, близким к реальному космическому путешествию: жёсткому ультрафиолетовому излучению, ионизирующей радиации, низкому давлению, почти нулевым температурам и контакту с марсианским грунтом.
Результаты оказались весьма впечатляющими. Особенно стойким проявил себя вид Aspergillus calidoustus — обычный «домашний» грибок, который можно встретить в вентиляционных системах и водопроводе. Его споры выдержали все испытания по отдельности. Погибали они лишь при одновременном воздействии экстремального холода и мощной радиации — то есть именно того сочетания, которое характерно для поверхности Марса при определённых условиях.
«Выживаемость микроорганизмов определяется не каким-то одним неблагоприятным фактором, а их совокупностью», — объяснил руководитель исследования, микробиолог из лаборатории NASA Кастури Венкатесваран.
Это первое исследование, в котором полный «маршрут» марсианской миссии — от сборочного цеха до поверхности планеты — был проверен на выживаемость грибков, а не только бактерий. Прежние работы касались исключительно бактерий, и методы дезинфекции космических аппаратов разрабатывались с расчётом именно на них.
Авторы работы подчёркивают: это не значит, что заражение Марса неизбежно. Однако результаты говорят о том, что существующие протоколы очистки космических аппаратов нужно пересмотреть с учётом грибков. Исследование опубликовано в журнале Applied and Environmental Microbiology.









